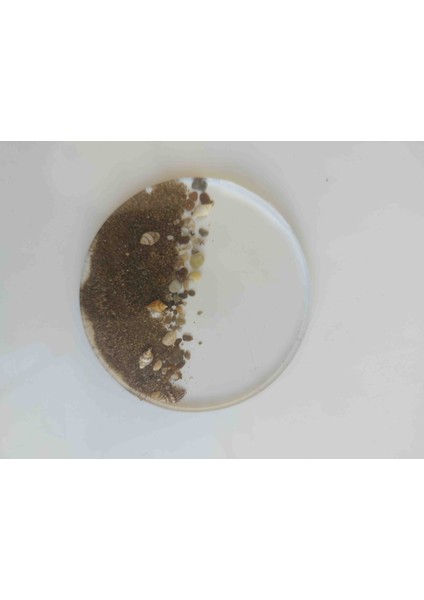

Karelim Home 1adet Bardak Altlığı Epoksi Şık Sunum Özel Seri
Henüz değerlendirilmemişİlk sen değerlendir
Satıcı: KARELİM HOME
10,0
10,0Satıcı puanı
Satıcı puanı, müşteri geri bildirimleri ve satıcının sipariş sürecindeki performansı dikkate alınarak hesaplanmaktadır.Renk: Kum Rengi
Bu üründen en az 2 adet satın alabilirsin.
Ürün Bilgileri
Dış Materyal
Döküm
Bakım Talimatları
Elde Yıkanmalıdır
Tema / Stil
Modern
Beden
Tek Ebat
Karelim Home 1adet Bardak Altlığı Epoksi Şık Sunum Özel Seri
2li Bardak Altlığı Epoksi Şık Sunum Özel Seri
- Zarif detaylarıyla süslenmiş, her türlü sofra düzenine şıklık katan epoksi bardak altlıkları.; - Özel seri tasarımıyla dikkat çeken bu ürünler, renk seçenekleri için özel sipariş alınması gerekmektedir.; - Yuvarlak şekliyle modern ve estetik bir görünüm sunar; her türlü içecek servisinde kullanıma uygundur.; - Epoksi materyali sayesinde dayanıklı yapısıyla uzun süreli kullanım vaat eder.; - Bakımının kolay olması için nemli bir bezle silerek temizlenebilir; böylece hijyenik kalmasını sağlayabilirsiniz.; - Üretiminde yerli malzemeler kullanılarak üretilmiş olup, Türk malı gururunu evinizde taşımanızı sağlar.;
Ürün özellikleri
Dış Materyal
Döküm
Bakım Talimatları
Elde Yıkanmalıdır
Tema / Stil
Modern
Beden
Tek Ebat
Bölme Sayısı
Yok
Şekil
Yuvarlak
Parça Sayısı
2
Malzeme
Epoksi
Set İçerik Adeti
1 Adet
Stok Adedi
100 adetten az
Diğer
Garanti Süresi (Ay)
1
Yurt Dışı Satış
Yok
Stok Kodu
HBCV0000A3Q66R
Hatalı içerik bildir
Popüler Aramalar